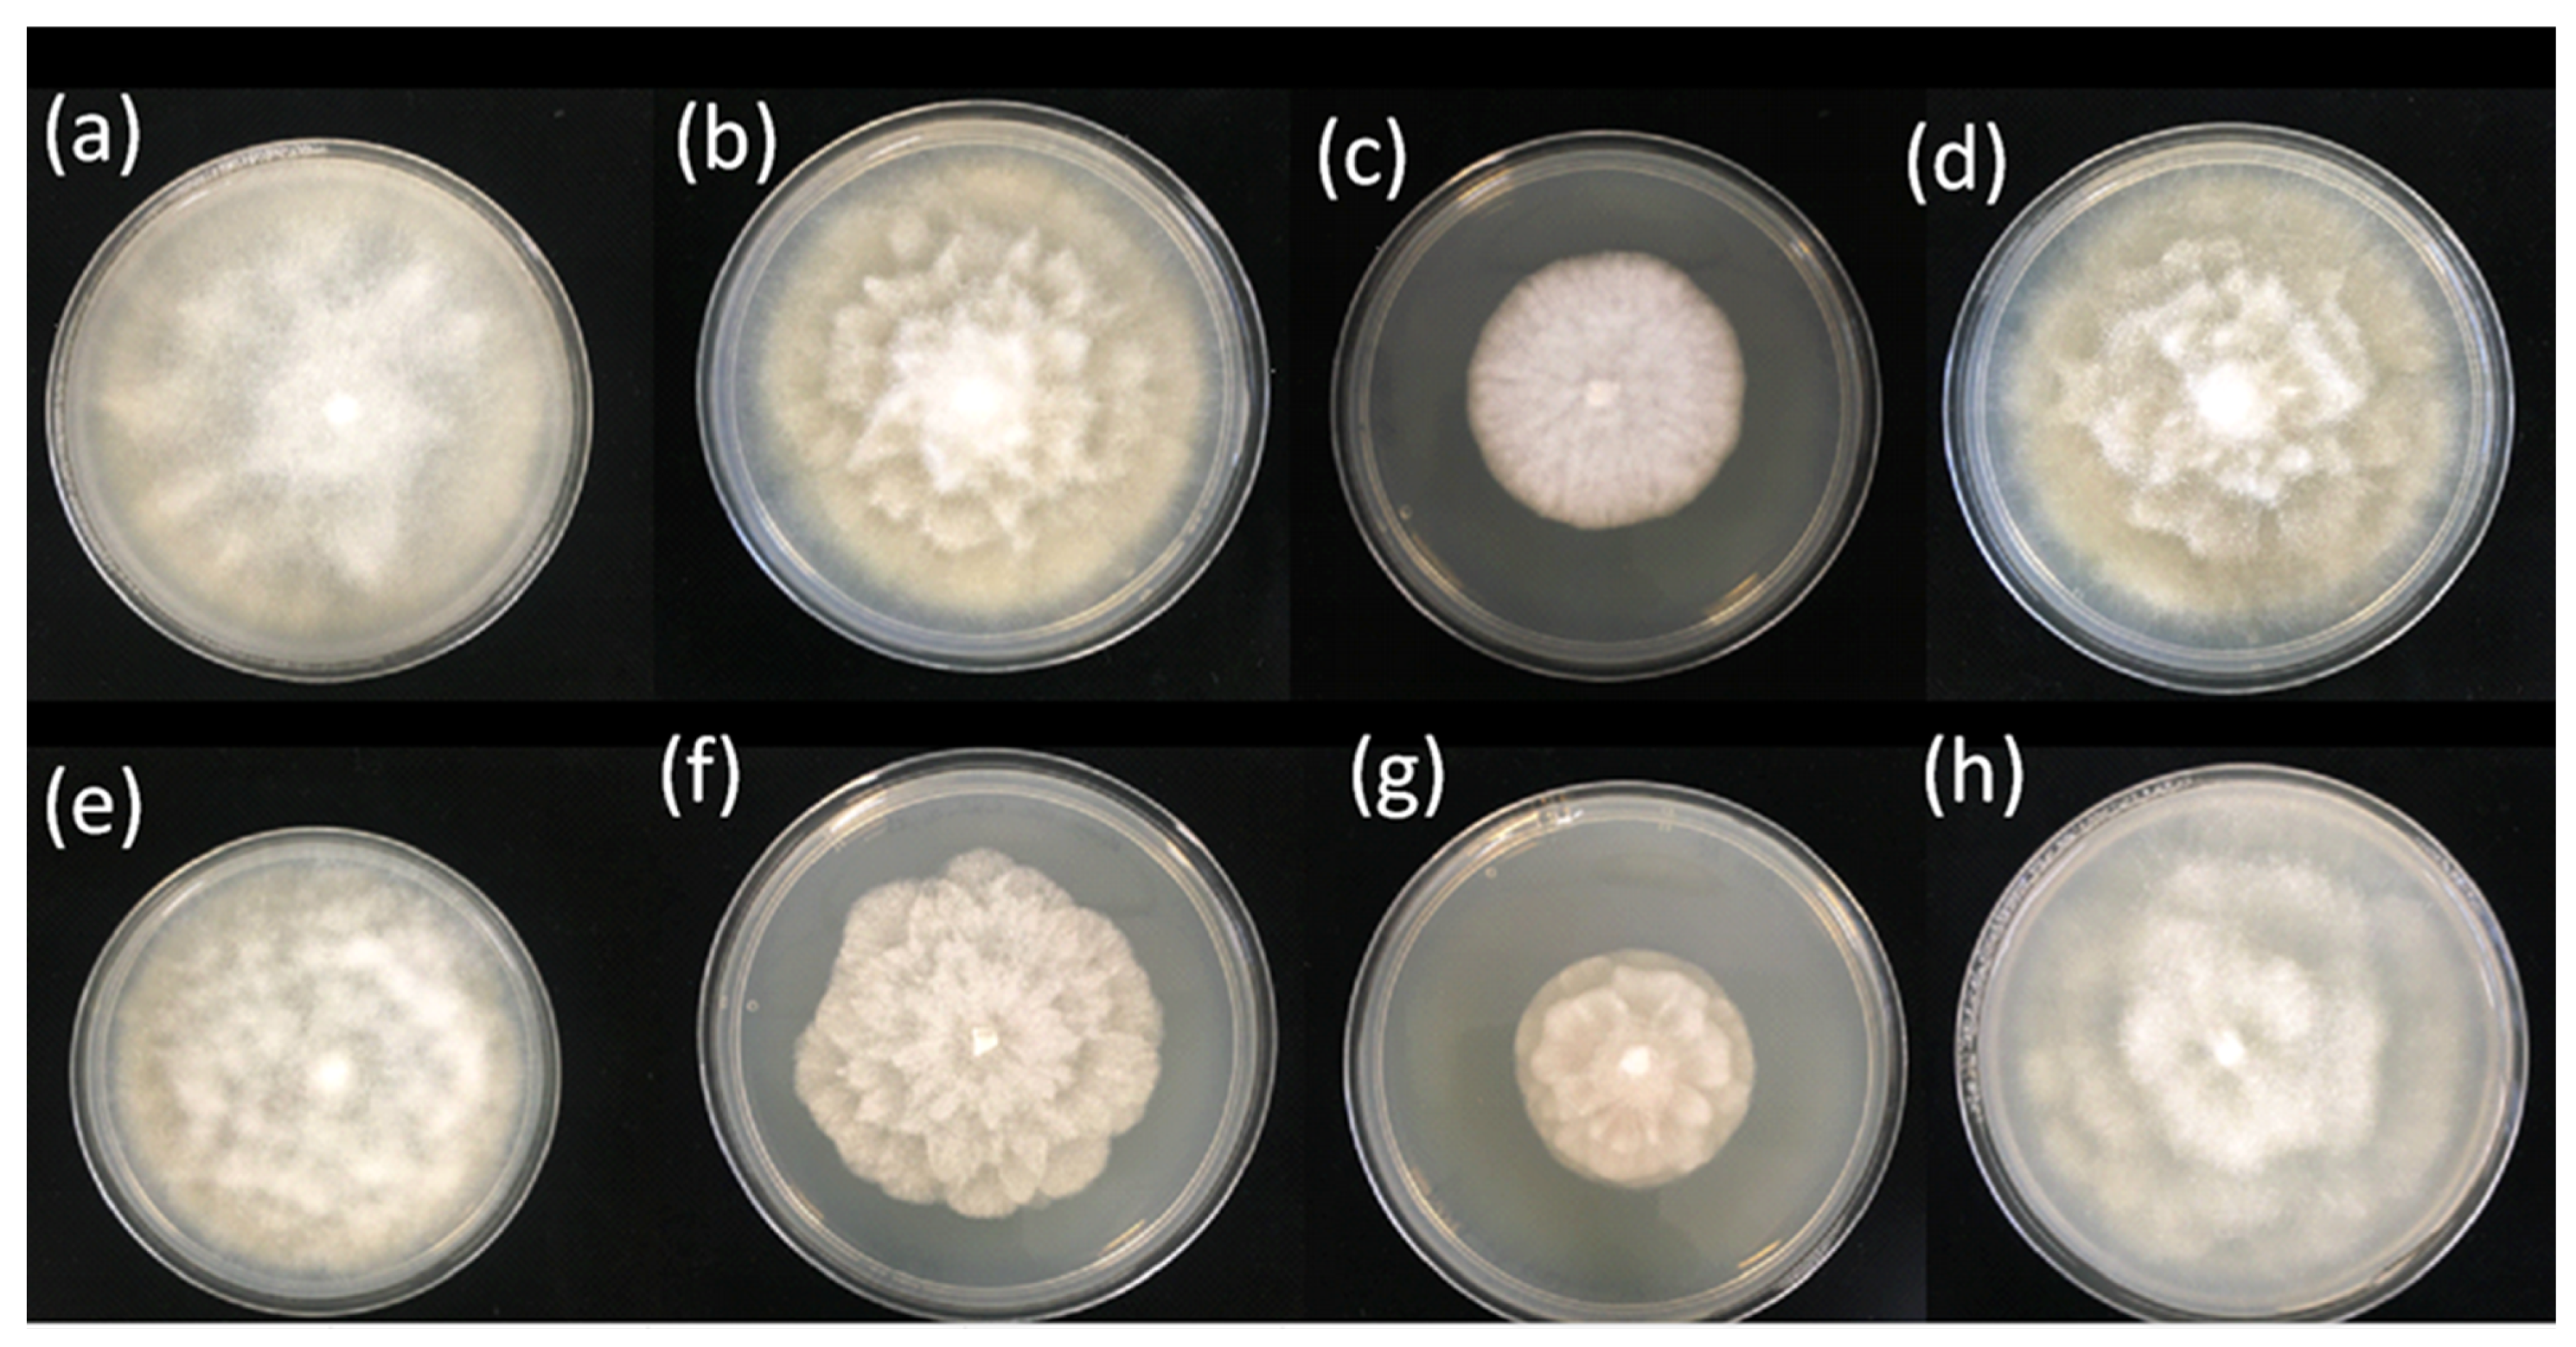
Horticulturae 09 00616 g004

Phytophthora in Horticultural Nursery Green Waste—A Risk to Plant Health
Abstract
1. Introduction
2. Materials and Methods
2.1. Nursery Sampling
2.2. Baiting Analyses
2.3. Metabarcoding Analyses
3. Results
4. Discussion
Author Contributions
Funding
Data Availability Statement
Acknowledgments
Conflicts of Interest
References
- Goss, E.M.; Carbone, I.; Grünwald, N.J. Ancient isolation and independent evolution of the three clonal lineages of the exotic sudden oak death pathogen Phytophthora ramorum. Mol. Ecol. 2009, 18, 1161–1174. [Google Scholar] [CrossRef] [PubMed]
- Bradshaw, R.E.; Bellgard, S.E.; Black, A.; Burns, B.R.; Gerth, M.L.; McDougal, R.L.; Scott, P.M.; Waipara, N.W.; Weir, B.S.; Williams, N.M.; et al. Phytophthora agathidicida: Research progress, cultural perspectives and knowledge gaps in the control and management of kauri dieback in New Zealand. Plant Pathology 2020, 69, 3–16. [Google Scholar] [CrossRef]
- Dobrowolski, M.P.; Tommerup, I.C.; Shearer, B.L.; O’Brien, P.A. Three clonal lineages of Phytophthora cinnamomi in Australia revealed by microsatellites. Phytopathology 2003, 93, 695–704. [Google Scholar] [CrossRef] [PubMed]
- Brasier, C.M. Phytophthora Biodiversity: How Many Phytophthora Species are There. Phytophthoras in Forests and Natural Ecosystems. In Proceedings of the Fourth Meeting of the International Union of Forest Research Organizations (IUFRO) Working Party S07.02.09, Monterey, CA, USA, 26–31 August 2007; United States Department of Agriculture: Albany, CA, USA, 2009; pp. 101–117. [Google Scholar]
- Yang, X.; Tyler, B.M.; Hong, C. An expanded phylogeny for the genus Phytophthora. IMA Fungus 2017, 8, 355–384. [Google Scholar] [CrossRef] [PubMed]
- Keriö, S.; Daniels, H.A.; Gómez-Gallego, M.; Tabima, J.F.; Lenz, R.R.; Søndreli, K.L.; Grünwald, N.J.; Williams, N.; Mcdougal, R.; LeBoldus, J.M. From genomes to forest management–tackling invasive Phytophthora species in the era of genomics. Can. J. Plant Pathol. 2020, 42, 1–29. [Google Scholar] [CrossRef]
- Harting, P. Recherches sur la Nature et les Causes de la Maladie des Pommes de Terre en 1845; CG Sulpke: Amsterdam, The Netherlands, 1846. [Google Scholar]
- Erwin, D.C.; Ribeiro, O.K. Phytophthora Diseases Worldwide; American Phytopathological Society Press: St. Paul, MN, USA, 1996. [Google Scholar]
- Antonelli, C.; Biscontri, M.; Tabet, D.; Vettraino, A.M. The Never-Ending Presence of Phytophthora Species in Italian Nurseries. Pathogens 2023, 12, 15. [Google Scholar] [CrossRef]
- Brasier, C.M. The biosecurity threat to the UK and global environment from international trade in plants. Plant Pathol. 2008, 57, 792–808. [Google Scholar] [CrossRef]
- Forest Research. Global Threats from Phytophthora s (PHYTO-THREATS). 2019. Available online: https://www.forestresearch.gov.uk/research/global-threats-fromPhytophthora-spp-phyto-threats/ (accessed on 20 April 2023).
- Green, S.; Cooke, D.E.; Dunn, M.; Barwell, L.; Purse, B.; Chapman, D.S.; Valatin, G.; Schlenzig, A.; Barbrook, J.; Pettitt, T.; et al. PHYTO-THREATS: Addressing threats to UK forests and woodlands from Phytophthora; identifying risks of spread in trade and methods for mitigation. Forests 2021, 12, 1617. [Google Scholar] [CrossRef]
- Scibetta, S.; Schena, L.; Chimento, A.; Cacciola, S.O.; Cooke, D.E. A molecular method to assess Phytophthora diversity in environmental samples. J. Microbiol. Methods 2012, 88, 356–368. [Google Scholar] [CrossRef]
- Khaliq, I.; Hardy, G.E.S.J.; White, D.; Burgess, T.I. eDNA from roots: A robust tool for determining Phytophthora communities in natural ecosystems. FEMS Microbiol. Ecol. 2018, 94, fiy048. [Google Scholar] [CrossRef]
- Riddell, C.E.; Frederickson-Matika, D.; Armstrong, A.C.; Elliot, M.; Forster, J.; Hedley, P.E.; Morris, J.; Thorpe, P.; Cooke, D.E.; Pritchard, L.; et al. Metabarcoding reveals a high diversity of woody host-associated Phytophthora s in soils at public gardens and amenity woodlands in Britain. PeerJ 2019, 7, e6931. [Google Scholar] [CrossRef] [PubMed]
- La Spada, F.; Cock, P.J.; Randall, E.; Pane, A.; Cooke, D.E.; Cacciola, S.O. DNA Metabarcoding and Isolation by Baiting Complement Each Other in Revealing Phytophthora Diversity in Anthropized and Natural Ecosystems. J. Fungi 2022, 8, 330. [Google Scholar] [CrossRef] [PubMed]
- Landa, B.B.; Arias-Giraldo, L.F.; Henricot, B.; Montes-Borrego, M.; Shuttleworth, L.A.; Pérez-Sierra, A. Diversity of Phytophthora species detected in disturbed and undisturbed British soils using high-throughput sequencing targeting ITS rRNA and COI mtDNA regions. Forests 2021, 12, 229. [Google Scholar] [CrossRef]
- Jung, T.; Orlikowski, L.; Henricot, B.; Abad-Campos, P.; Aday, A.G.; Aguín Casal, O.; Bakonyi, J.; Cacciola, S.O.; Cech, T.; Chavarriaga, D.; et al. Widespread Phytophthora infestations in European nurseries put forest, semi-natural and horticultural ecosystems at high risk of Phytophthora diseases. For. Pathol. 2016, 46, 134–163. [Google Scholar] [CrossRef]
- Longmire, J.L.; Maltbie, M.; Baker, R.J. Use of ”Lysis Buffer” in DNA Isolation and Its Implication for Museum Collections; Museum of Texas Tech University: Lubbock, TX, USA, 1997. [Google Scholar]
- Pérez-Sierra, A.; Jung, M.H.; Jung, T. Survey and monitoring of Phytophthora species in natural ecosystems: Methods for sampling, isolation, purification, storage, and pathogenicity tests. In Plant Pathology: Method and Protocols (13–49); Springer: New York, NY, USA, 2022. [Google Scholar]
- Elliot, C.G.; Hendrie, M.R.; Knights, B.A. The sterol requirement of Phytophthora cactorum. Microbiology 1966, 42, 425–435. [Google Scholar] [CrossRef]
- Jeffers, S.N. Protocol 07-11.1: V8 agar (V8A) or Broth. Laboratory Protocols for Phytophthora species (1–2); The American Phytopathological Society: St. Paul, MN, USA, 2015. [Google Scholar]
- White, T.J.; Bruns, T.; Lee, S.J.W.T.; Taylor, J. Amplification and direct sequencing of fungal ribosomal RNA genes for phylogenetics. In PCR Protocols: A Guide to Methods and Applications; Academic Press: Amsterdam, The Netherlands, 1990; Volume 18, pp. 315–322. [Google Scholar]
- Cooke, D.E.L.; Drenth, A.; Duncan, J.M.; Wagels, G.; Brasier, C.M. A molecular phylogeny of Phytophthora and related oomycetes. Fungal Genet. Biol. 2000, 30, 17–32. [Google Scholar] [CrossRef]
- Cock, P.J.; Cooke, D.E.; Thorpe, P.; Pritchard, L. THAPBI PICT-a fast, cautious, and accurate metabarcoding analysis pipeline. bioRxiv 2023. in print. [Google Scholar] [CrossRef]
- Jung, T.; Jung, M.H.; Cacciola, S.O.; Cech, T.; Bakonyi, J.; Seress, D.; Mosca, S.; Schena, L.; Seddaiu, S.; Pane, A.; et al. Multiple new cryptic pathogenic Phytophthora species from Fagaceae forests in Austria, Italy and Portugal. IMA Fungus 2017, 8, 219–244. [Google Scholar] [CrossRef]
- Werres, S.; Marwitz, R.; In’t Veld, W.A.M.; De Cock, A.W.; Bonants, P.J.; De Weerdt, M.; Themann, K.; Ilieva, E.; Baayen, R.P. Phytophthora ramorum sp. nov., a new pathogen on Rhododendron and Viburnum. Mycol. Res. 2001, 105, 1155–1165. [Google Scholar] [CrossRef]
- Webber, J.F.; Mullett, M.; Brasier, C.M. Dieback and mortality of plantation Japanese larch (Larix kaempferi) associated with infection by Phytophthora ramorum. New Dis. Rep. 2010, 22, 19. [Google Scholar] [CrossRef]
- Brasier, C.; Webber, J. Sudden larch death. Nature 2010, 466, 824–825. [Google Scholar] [CrossRef] [PubMed]
- Green, S.; Elliot, M.; Armstrong, A.; Hendry, S.J. Phytophthora austrocedrae emerges as a serious threat to juniper (Juniperus communis) in Britain. Plant Pathol. 2015, 64, 456–466. [Google Scholar] [CrossRef]
- Safaiefarahani, B.; Mostowfizadeh-Ghalamfarsa, R.S.T.J.; Hardy, G.S.J.; Burgess, T.I. Re-evaluation of the Phytophthora cryptogea species complex and the description of a new species, Phytophthora pseudocryptogea sp. nov. Mycol. Prog. 2015, 14, 1–12. [Google Scholar] [CrossRef]
- Lebert, H.; Cohn, F. Über die Fäule der Cactusstämme. Beiträge Biol. Pflanz 1870, 1, 51–57. [Google Scholar]
- Jung, T.; Burgess, T.I. Re-evaluation of Phytophthora citricola isolates from multiple woody hosts in Europe and North America reveals a new species, Phytophthora plurivora sp. nov. Pers. Mol. Phylogeny Evol. Fungi 2009, 22, 95–110. [Google Scholar] [CrossRef]
- Scott, P.M.; Burgess, T.I.; Barber, P.A.; Shearer, B.L.; Stukely, M.J.C.; Hardy, G.S.J.; Jung, T. Phytophthora multivora sp. nov., a new species recovered from declining Eucalyptus, Banksia, Agonis and other plant specie in Western Australia. Pers. Mol. Phylogeny Evol. Fungi 2009, 22, 1–13. [Google Scholar] [CrossRef]
- Klebahn, H. Die neue Zweig-und Knospenkrankheit. In Krankheiten des Flieders; Borntraeger: Stuttgart, Germany, 1909; pp. 18–75. [Google Scholar]
- Cooke, D.E.L. Threats Posed by Phytophthora to Scottish Plant Health: A Review of Previous Findings, Pathways of Entry and Further Spread and the Status of Diagnostic Techniques; RESAS Phytophthora Risk Review Report Commissioned by the Scottish Government; Plant Health Service: Dundee, UK, 2015. [Google Scholar]
- Prigigallo, M.I.; Mosca, S.; Cacciola, S.O.; Cooke, D.E.L.; Schena, L. Molecular analysis of Phytophthora diversity in nursery-grown ornamental and fruit plants. Plant Pathol. 2015, 64, 1308–1319. [Google Scholar] [CrossRef]
- Carne, J.R. Phytophthora hibernalis. Soc. W. Australia 1925, 12, 13. [Google Scholar]
- Forest Research Tree Health Advisory Database. Available online: https://www.forestresearch.gov.uk/services/tree-health-diagnostic-and-advisory-service/ (accessed on 20 April 2023).
- Santilli, E.; Riolo, M.; La Spada, F.; Pane, A.; Cacciola, S.O. First report of root rot caused by Phytophthora bilorbang on Olea europaea in Italy. Plants 2020, 9, 826. [Google Scholar] [CrossRef]
- Ersek, T.; English, J.T.; Schoelz, J.E. Creation of species hybrids of Phytophthora with modified host ranges by zoospore fusion. Phytopathology 1995, 85, 1343–1347. [Google Scholar] [CrossRef]
- Elliot, M.; Green, S.; Litterick, A.; Yeomans, A. Identifying the Plant Health Risks Associated with Plant Waste Disposal and Peat-Free Growing Media and Developing Best Practice Guidance for Waste Disposal and Composting Across Sectors: Project Final Report. PHC2021/02. Scotland’s Centre of Expertise for Plant Health (PHC). 2023. Available online: https://www.planthealthcentre.scot/sites/www.planthealthcentre.scot/files/2023-03/PHC2021_02%20Plant_waste_disposal_Policy_Summary.pdf (accessed on 10 April 2023).
- Plant Healthy. Plant Healthy Certification Scheme. 2022. Available online: https://planthealthy.org.uk/ (accessed on 22 June 2022).

| Nursery 1 | Nursery 2 | Nursery 3 | |
|---|---|---|---|
| Purpose | Non-commercial specialist horticultural nursery | Commercial nursery | Commercial nursery |
| Irrigation source | Mains | Mains stored in open tank | Stream water in pond |
| % of stock propagated on site | 99 | 0 | 50 |
| % of stock from UK | 1 | 72 | 10 |
| % of stock from EU | 0 | 28 | 40 |
| % of stock from outside EU | 0 | 0 | 1 |
| Waste disposal method | Waste composted on site in concrete holding area | Stored at back of nursery site near stream and hedgerow | Stored at back of nursery site near stream and woodland |
| Other biosecurity measures | Disinfection stations, mats and quarantine area for new stock. | No disinfection stations, mats and no quarantine area. | No disinfection stations, mats and no quarantine area. |
| Site | Sample Type | Species Detected with Baiting, Clade, and Sub-Clade in Brackets | Species Detected with Metabarcoding, Clade, and Sub-Clade in Brackets | Total Number of Species per Sample |
|---|---|---|---|---|
| N1 | 4 water samples 6 solid waste samples No root samples | ND | ND | 0 |
| N2 | Water (on site irrigation water/field blank) | NA | P. austrocedri (clade 8) | 3 |
| P. bilorbang (clade 6b) | ||||
| P. lacustris (clade 6b) | ||||
| Water (stream bordering nursery site) | P. bilorbang (clade 6b) | P. austrocedri (clade 8d) | 3 | |
| P. lacustris (clade 6b) | ||||
| Root (discarded cypress root ball) | NA | P. castanetorum (clade 12) * | 3 | |
| P. gonapodyides (clade 6b) | ||||
| P. syringae (clade 8d) | ||||
| Root (discarded yew root ball) | NA | P. cryptogea (clade 8a) | 2 | |
| P. pseudocryptogea (clade 8a) | ||||
| Root (unidentified broadleaf root ball) | NA | P. pseudocryptogea (clade 8a) | 1 | |
| Solid waste 1 (horizon A) | P. chlamydospora (clade 6b) | ND | 1 | |
| Solid waste 1 (horizon B) | ND | P. citricola (clade 2c) P. plurivora (clade 2c) | 4 | |
| P. chlamydospora (clade 6b) | ||||
| P. castanetorum (clade 12) * | ||||
| Solid waste 1 (horizon C) | P. ramorum (clade 8c) | P. syringae (clade 8d) | 6 | |
| P. pseudocryptogea (clade 8a) | P. plurivora (clade 2c) | |||
| P. chlamydospora (clade 8a) | ||||
| P. hibernalis (clade 8c) | ||||
| Solid waste 2 (horizon A) | ND | P. megasperma (clade 6b) | 1 | |
| Solid waste 2 (horizon B) | ND | P. syringae (clade 8d) | 3 | |
| P. castanetorum (clade 12) * | ||||
| P. cactorum (clade 1a) | ||||
| Solid waste 2 (horizon C) | P. chlamydospora (clade 6b) | P. syringae (clade 8d) | 5 | |
| P. gonapodyides (clade 6b) | ||||
| P. ramorum (clade 8c) | ||||
| P. gregata (clade 6b) | ||||
| N3 | Water (puddle) | NA | P. infestans (clade 1c) | 4 |
| P. chlamydospora (clade 6b) | ||||
| P. gonapodyides (clade 6b) | ||||
| P. syringae (clade 8d) | ||||
| Water (puddle) | P. chlamydospora (clade 6b) | ND | 1 | |
| Root (discarded pine root ball) | NA | P. hibernalis (clade 8c) | 1 | |
| Solid waste 3 (horizon A) | P. gonapodyides (clade 6b) | ND | 1 | |
| Solid waste 3 (horizon B) | P. ramorum (clade 8c) | ND | 1 | |
| Solid waste 3 (horizon C) | P. chlamydospora (clade 6b) | P. cactorum (clade 1a) | 5 | |
| P. gonapodyides (clade 6b) | P. syringae (clade 8d) | |||
| P. ramorum (clade 8c) | ||||
| Solid waste 4 (horizon A) | P. chlamydospora (clade 6b) | ND | 3 | |
| P. gonapodyides (clade 6b) | ||||
| P. ramorum (clade 8c) | ||||
| Solid waste 4 (horizon B) | P. chlamydospora (clade 6b) | P. multivora (clade 2c) | 5 | |
| P. megasperma (clade 6b) | P. syringae (clade 8d) | |||
| P. gonapogyides (clade 6b) | P. gonapodyides (clade 6b) | |||
| Solid waste 4 (horizon C) | P. chlamydospora (clade 6b) | ND | 2 | |
| P. ramorum (clade 8c) |
Disclaimer/Publisher’s Note: The statements, opinions and data contained in all publications are solely those of the individual author(s) and contributor(s) and not of MDPI and/or the editor(s). MDPI and/or the editor(s) disclaim responsibility for any injury to people or property resulting from any ideas, methods, instructions or products referred to in the content. |
© 2023 by the authors. Licensee MDPI, Basel, Switzerland. This article is an open access article distributed under the terms and conditions of the Creative Commons Attribution (CC BY) license (https://creativecommons.org/licenses/by/4.0/).
Share and Cite
Schiffer-Forsyth, K.; Frederickson Matika, D.; Hedley, P.E.; Cock, P.J.A.; Green, S. Phytophthora in Horticultural Nursery Green Waste—A Risk to Plant Health. Horticulturae 2023, 9, 616. https://doi.org/10.3390/horticulturae9060616
Schiffer-Forsyth K, Frederickson Matika D, Hedley PE, Cock PJA, Green S. Phytophthora in Horticultural Nursery Green Waste—A Risk to Plant Health. Horticulturae. 2023; 9(6):616. https://doi.org/10.3390/horticulturae9060616
Chicago/Turabian StyleSchiffer-Forsyth, Kadiatou, Debra Frederickson Matika, Pete E. Hedley, Peter J. A. Cock, and Sarah Green. 2023. "Phytophthora in Horticultural Nursery Green Waste—A Risk to Plant Health" Horticulturae 9, no. 6: 616. https://doi.org/10.3390/horticulturae9060616
APA StyleSchiffer-Forsyth, K., Frederickson Matika, D., Hedley, P. E., Cock, P. J. A., & Green, S. (2023). Phytophthora in Horticultural Nursery Green Waste—A Risk to Plant Health. Horticulturae, 9(6), 616. https://doi.org/10.3390/horticulturae9060616
